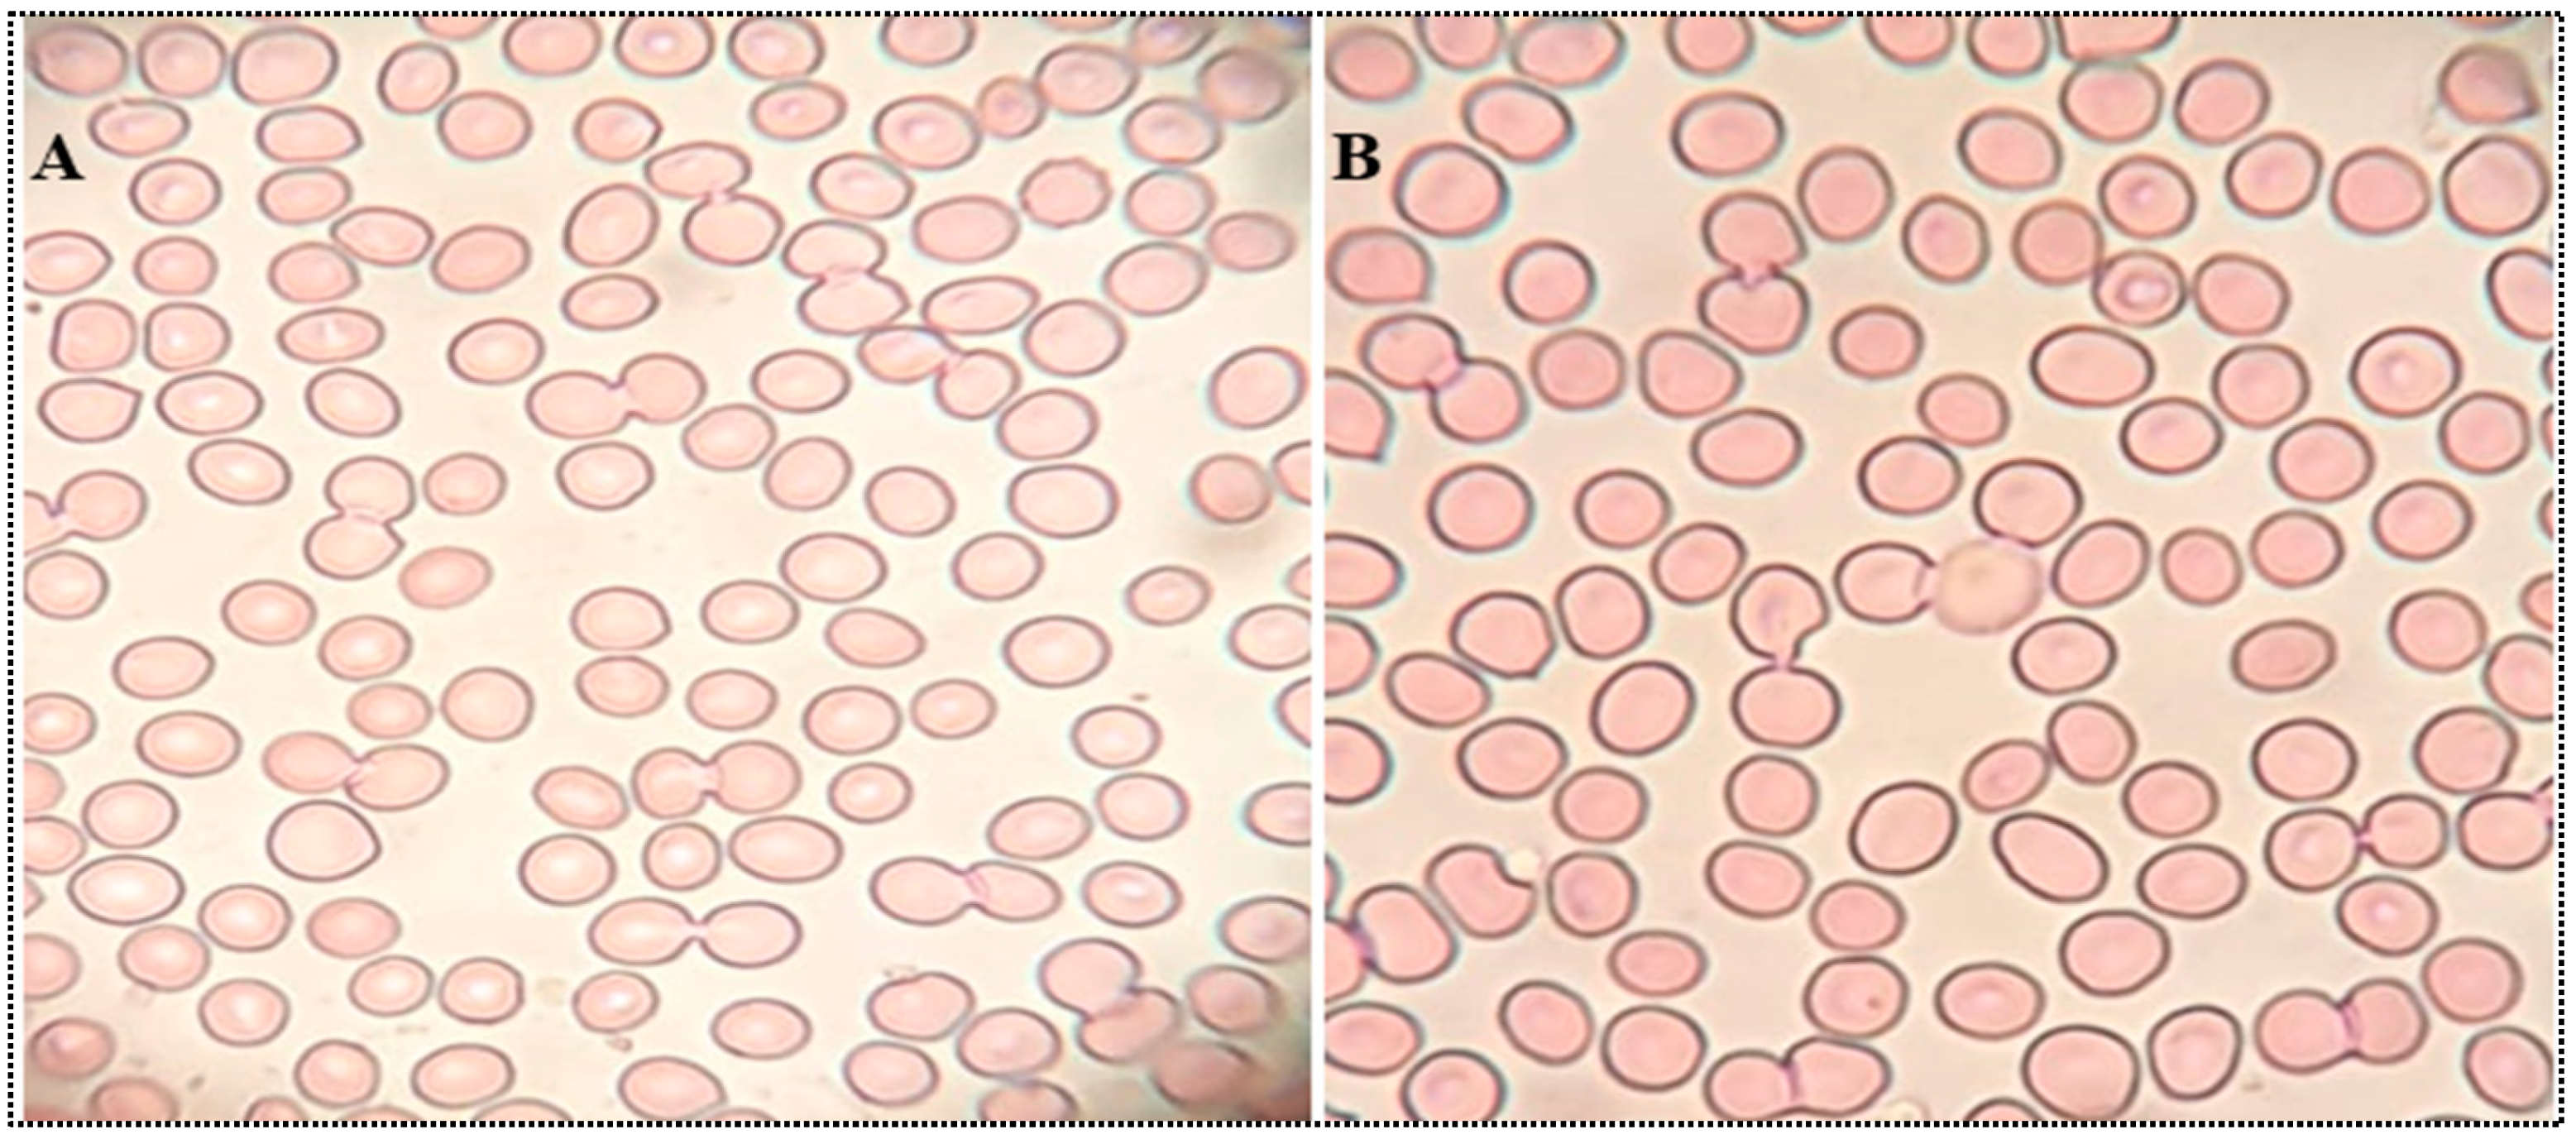
Gels 08 00418 g011

Formulation and Evaluation of Moxifloxacin Loaded Bilosomes In-Situ Gel: Optimization to Antibacterial Evaluation
Abstract
:1. Introduction
2. Results and Discussion
2.1. Optimization
2.1.1. Effects of SDC (A), Cremophor EL (B), and Span 60 (C) on Hydrodynamic Diameter (Y1)
2.1.2. Effect of SDC (A), Cremophor EL (B), and Span 60 (C) on Entrapment Efficiency (Y2)
2.1.3. Effect of SDC (A), Cremophor EL (B), and Span 60 (C) on PDI (Y3)
2.1.4. Selection of Optimized Formulation (MX-BSop)

2.2. Hydrodynamic Diameter and Zeta Potential
2.3. Development of In Situ Gel
2.4. MX-BS-Ig Characterization
2.4.1. DSC Study
2.4.2. FTIR Spectroscopy Study
2.4.3. In Vitro Dissolution Study
2.4.4. Bio-Adhesive Study
2.4.5. Permeation Study
2.4.6. Corneal Hydration Study
2.4.7. Histopathological Study
2.4.8. HET-CAM Study
2.4.9. Isotonicity Test
2.4.10. Antimicrobial Activity Evaluation
2.4.11. Minimum Inhibitory Concentration (MIC)
3. Conclusions
4. Material and Experimental
4.1. Materials
4.2. Experimental
4.2.1. Optimization
4.2.2. Development of MX-BS
4.3. Characterization
4.3.1. Vesicle Characterization
4.3.2. Encapsulation Efficiency
4.3.3. Drug Loading
4.3.4. Development of MX-BS In Situ Gel (MX-BS-Ig)
4.4. MX-BS-Ig Characterization
4.4.1. Differential Scanning Calorimetry (DSC)
4.4.2. Fourier-Transform Infrared Spectroscopy (FTIR)
4.4.3. In Vitro Dissolution Study
4.4.4. Bio-Adhesive Study
4.4.5. Corneal Permeation
4.4.6. Corneal Hydration Study
4.4.7. Histopathological Study
4.4.8. Chorioallantoic Membrane Study (CAM)
4.4.9. Isotonicity Test
4.4.10. Antimicrobial Activity Evaluation
4.4.11. Minimum Inhibitory Concentration
Supplementary Materials
Author Contributions
Funding
Institutional Review Board Statement
Informed Consent Statement
Data Availability Statement
Acknowledgments
Conflicts of Interest
References
- Pandey, M.; Choudhury, H.; Aziz, A.B.A.; Bhattamisra, S.; Gorain, B.; Su, J.; Tan, C.; Chin, W.; Yip, K. Potential of Stimuli-Responsive In Situ Gel System for Sustained Ocular Drug Delivery: Recent Progress and Contemporary Research. Polymers 2021, 13, 1340. [Google Scholar] [CrossRef] [PubMed]
- Souto, E.B.; Dias-Ferreira, J.; López-Machado, A.; Ettcheto, M.; Cano, A.; Espuny, A.C.; Espina, M.; Garcia, M.L.; Sánchez-López, E. Advanced Formulation Approaches for Ocular Drug Delivery: State-Of-The-Art and Recent Patents. Pharmaceutics 2019, 11, 460. [Google Scholar] [CrossRef] [PubMed] [Green Version]
- Dave, V.; Paliwal, S. A novel approach to formulation factor of aceclofenac eye drops efficiency evaluation based on physi-cochemical characteristics of in vitro and in vivo permeation. Saudi Pharm. J. 2014, 22, 240–245. [Google Scholar] [CrossRef] [PubMed] [Green Version]
- Al-Kinani, A.A.; Zidan, G.; Elsaid, N.; Seyfoddin, A.; Alani, A.W.G.; Alany, R.G. Ophthalmic gels: Past, present and future. Adv. Drug Deliv. Rev. 2018, 126, 113–126. [Google Scholar] [CrossRef] [Green Version]
- Polat, H.K.; Pehlivan, S.B.; Özkul, C.; Calamak, S.; Ozturk, N.; Aytekin, E.; Fırat, A.; Ulubayram, K.; Kocabeyoğlu, S.; Irkeç, M.; et al. Development of besifloxacin HCl loaded nanofibrous ocular inserts for the treatment of bacterial keratitis: In vitro, ex vivo and in vivo evaluation. Int. J. Pharm. 2020, 585, 119552. [Google Scholar] [CrossRef]
- Adrianto, M.F.; Annuryanti, F.; Wilson, C.G.; Sheshala, R.; Thakur, R.R.S. In vitro dissolution testing models of ocular implants for posterior segment drug delivery. Drug Deliv. Transl. Res. 2021, 12, 1355–1375. [Google Scholar] [CrossRef]
- Duxfield, L.; Sultana, R.; Wang, R.; Englebretsen, V.; Deo, S.; Swift, S.; Rupenthal, I.; Al-Kassas, R. Development of gatifloxacin-loaded cationic polymeric nanoparticles for ocular drug delivery. Pharm. Dev. Technol. 2016, 21, 172–179. [Google Scholar] [CrossRef]
- Gonzalez-Pizarro, R.; Carvajal-Vidal, P.; Bellowa, L.H.; Calpena, A.C.; Espina, M.; García, M.L. In-situ forming gels containing fluorometholone-loaded polymeric nanoparticles for ocular inflammatory conditions. Colloids Surf. B: Biointerfaces 2018, 175, 365–374. [Google Scholar] [CrossRef]
- Landucci, E.; Bonomolo, F.; De Stefani, C.; Mazzantini, C.; Pellegrini-Giampietro, D.E.; Bilia, A.R.; Bergonzi, M.C. Preparation of Liposomal Formulations for Ocular Delivery of Thymoquinone: In Vitro Evaluation in HCEC-2 e HConEC Cells. Pharmaceutics 2021, 13, 2093. [Google Scholar] [CrossRef]
- Owodeha-Ashaka, K.; Ilomuanya, M.O.; Iyire, A. Evaluation of sonication on stability-indicating properties of optimized pilocarpine hydrochloride-loaded niosomes in ocular drug delivery. Prog. Biomater. 2021, 10, 207–220. [Google Scholar] [CrossRef]
- Allam, A.; Elsabahy, M.; El Badry, M.; Eleraky, N.E. Betaxolol-loaded niosomes integrated within pH-sensitive in situ forming gel for management of glaucoma. Int. J. Pharm. 2021, 598, 120380. [Google Scholar] [CrossRef] [PubMed]
- Youshia, J.; Kamel, A.O.; El Shamy, A.; Mansour, S. Gamma sterilization and in vivo evaluation of cationic nanostructured lipid carriers as potential ocular delivery systems for antiglaucoma drugs. Eur. J. Pharm. Sci. 2021, 163, 105887. [Google Scholar] [CrossRef] [PubMed]
- Kumari, S.; Dandamudi, M.; Rani, S.; Behaeghel, E.; Behl, G.; Kent, D.; O’Reilly, N.; O’Donovan, O.; McLoughlin, P.; Fitzhenry, L. Dexamethasone-Loaded Nanostructured Lipid Carriers for the Treatment of Dry Eye Disease. Pharmaceutics 2021, 13, 905. [Google Scholar] [CrossRef] [PubMed]
- Youssef, A.A.A.; Cai, C.; Dudhipala, N.; Majumdar, S. Design of Topical Ocular Ciprofloxacin Nanoemulsion for the Man-agement of Bacterial Keratitis. Pharmaceuticals 2021, 14, 210. [Google Scholar] [CrossRef] [PubMed]
- Kassaee, S.N.; Mahboobian, M.M. Besifloxacin-loaded ocular nanoemulsions: Design, formulation and efficacy evaluation. Drug Deliv. Transl. Res. 2022, 12, 229–239. [Google Scholar] [CrossRef]
- Salem, H.F.; Ali, A.A.; Hegazy, A.M.; Sadek, A.A.; Aboud, H.M. Harnessing of Doxylamine Succinate/Pyridoxine Hydrochloride-Dual Laden Bilosomes as a Novel Combinatorial Nanoparadigm for Intranasal Delivery: In Vitro Optimization and In Vivo Phar-macokinetic Appraisal. J. Pharm. Sci. 2022, 111, 794–809. [Google Scholar] [CrossRef]
- Nair, A.; Shah, J.; Al-Dhubiab, B.; Jacob, S.; Patel, S.; Venugopala, K.; Morsy, M.; Gupta, S.; Attimarad, M.; Sreeharsha, N.; et al. Clarithromycin Solid Lipid Nanoparticles for Topical Ocular Therapy: Optimization, Evaluation and In Vivo Studies. Pharmaceutics 2021, 13, 523. [Google Scholar] [CrossRef]
- Abdelbary, A.A.; Abd-Elsalam, W.H.; Al-Mahallawi, A.M. Fabrication of novel ultradeformable bilosomes for enhanced ocular delivery of terconazole: In vitro characterization, ex vivo permeation and in vivo safety assessment. Int. J. Pharm. 2016, 513, 688–696. [Google Scholar] [CrossRef]
- Wilkhu, J.S.; McNeil, S.E.; Anderson, D.E.; Perrie, Y. Characterization and optimization of bilosomes for oral vaccine delivery. J. Drug Target. 2013, 21, 291–299. [Google Scholar] [CrossRef] [Green Version]
- Al-Mahallawi, A.M.; Abdelbary, A.A.; Aburahma, M.H. Investigating the potential of employing bilosomes as a novel vesicular carrier for transdermal delivery of tenoxicam. Int. J. Pharm. 2015, 485, 329–340. [Google Scholar] [CrossRef]
- Nair, A.B.; Shah, J.; Jacob, S.; Al-Dhubiab, B.E.; Sreeharsha, N.; Morsy, M.A.; Gupta, S.; Attimarad, M.; Shinu, P.; Venugopala, K.N. Experimental design, formulation and in vivo evaluation of a novel topical in situ gel system to treat ocular infections. PLoS ONE 2021, 16, e0248857. [Google Scholar] [CrossRef]
- Gashti, M.P.; Dehghan, N. Gel diffusion-inspired biomimetic calcium iodate/gelatin composite particles: Structural characterization and antibacterial activity. J. Solid State Chem. 2020, 285, 121262. [Google Scholar] [CrossRef]
- Noralian, Z.; Gashti, M.P.; Moghaddam, M.R.; Tayyeb, H.; Erfanian, I. Ultrasonically developed silver/iota-carrageenan/cotton bionanocomposite as an efficient material for biomedical applications. Int. J. Biol. Macromol. 2021, 180, 439–457. [Google Scholar] [CrossRef] [PubMed]
- Kesarla, R.; Tank, T.; Vora, P.A.; Shah, T.; Parmar, S.; Omri, A. Preparation and evaluation of nanoparticles loaded ophthalmic in situ gel. Drug Deliv. 2016, 23, 2363–2370. [Google Scholar] [CrossRef] [PubMed]
- Stroman, D.W.; Dajcs, J.J.; Cupp, G.A.; Schlech, B.A. In Vitro and In Vivo Potency of Moxifloxacin and Moxifloxacin Ophthalmic Solution 0.5%, A New Topical Fluoroquinolone. Surv. Ophthalmol. 2005, 50, S16–S31. [Google Scholar] [CrossRef]
- Gan, L.; Wang, J.; Jiang, M.; Bartlett, H.; Ouyang, D.; Eperjesi, F.; Liu, J.; Gan, Y. Recent advances in topical ophthalmic drug delivery with lipid-based nanocarriers. Drug Discov. Today 2013, 18, 290–297. [Google Scholar] [CrossRef]
- Khan, F.U.; Nasir, F.; Iqbal, Z.; Neau, S.; Khan, I.; Hassan, M.; Iqbal, M.; Ullah, A.; Khan, S.I.; Sakhi, M. Improved Ocular Bioavailability of Moxifloxacin HCl using PLGA Nanoparticles: Fabrication, Characterization, In-vitro and In-vivo Evaluation. Iran. J. Pharm. Res. IJPR 2021, 20, 592–608. [Google Scholar]
- Mudgil, M.; Pawar, P.K. Preparation and in-vitro/ex-vivo evaluation of moxifloxacin-loaded PLGA nanosuspensions for ophthalmic application. Sci. Pharm. 2013, 81, 591–606. [Google Scholar] [CrossRef] [Green Version]
- Albash, R.; Abdellatif, M.M.; Hassan, M.; Badawi, M.N. Tailoring Terpesomes and Leciplex for the Effective Ocular Conveyance of Moxifloxacin Hydrochloride (Comparative Assessment): In-vitro, Ex-vivo, and In-vivo Evaluation. Int. J. Nanomed. 2021, 16, 5247–5263. [Google Scholar] [CrossRef]
- Asfour, M.H.; El-Alim, S.H.A.; Awad, G.E.A.; Kassem, A.A. Chitosan/β-glycerophosphate in situ forming thermo-sensitive hydrogel for improved ocular delivery of moxifloxacin hydrochloride. Eur. J. Pharm. Sci. 2021, 167, 106041. [Google Scholar] [CrossRef]
- Ferreira, K.S.A.; Dos Santos, B.M.A.; Lucena, N.D.P.; Ferraz, M.S.; Ferraz-Carvalho, R.; Júnior, A.P.D.; Santos-Magalhaes, N.; Lira, R.P.C.; Ozek, D.; Kemer, O.E.; et al. Ocular delivery of moxifloxacin-loaded liposomes. Arq. Bras. de Oftalmol. 2018, 81, 510–513. [Google Scholar] [CrossRef] [PubMed]
- Sohrabi, S.; Haeri, A.; Mahboubi, A.; Mortazavi, A.; Dadashzadeh, S. Chitosan gel-embedded moxifloxacin niosomes: An efficient antimicrobial hybrid system for burn infection. Int. J. Biol. Macromol. 2016, 85, 625–633. [Google Scholar] [CrossRef] [PubMed]
- Darvishi, M.; Farahani, S.; Haeri, A. Moxifloxacin-Loaded Lipidic Nanoparticles for Antimicrobial Efficacy. Curr. Pharm. Des. 2021, 27, 135–140. [Google Scholar] [CrossRef] [PubMed]
- Verlee, A.; Mincke, S.; Stevens, C.V. Recent developments in antibacterial and antifungal chitosan and its derivatives. Carbohydr. Polym. 2017, 164, 268–283. [Google Scholar] [CrossRef]
- Cagri, A.; Ustunol, Z.; Ryser, E.T. Antimicrobial Edible Films and Coatings. J. Food Prot. 2004, 67, 833–848. [Google Scholar] [CrossRef]
- Modi, D.; Mohammad; Warsi, M.H.; Garg, V.; Bhatia, M.; Kesharwani, P.; Jain, G.K. Formulation development, optimization, and in vitro assessment of thermoresponsive ophthalmic pluronic F127-chitosan in situ tacrolimus gel. J. Biomater. Sci. Polym. Ed. 2021, 32, 1678–1702. [Google Scholar] [CrossRef]
- Jain, P.; Jaiswal, C.P.; Mirza, M.A.; Anwer, K.; Iqbal, Z. Preparation of levofloxacin loaded in situ gel for sustained ocular delivery: In vitro and ex vivo evaluations. Drug Dev. Ind. Pharm. 2020, 46, 50–56. [Google Scholar] [CrossRef]
- Gupta, H.; Aqil, M.; Khar, R.K.; Ali, A.; Bhatnagar, A.; Mittal, G. An alternative in situ gel-formulation of levofloxacin eye drops for prolong ocular retention. J. Pharm. Bioallied Sci. 2015, 7, 9–14. [Google Scholar] [CrossRef]
- El Zaafarany, G.M.; Awad, G.A.S.; Holayel, S.M.; Mortada, N.D. Role of edge activators and surface charge in developing ultrade-formable vesicles with enhanced skin delivery. Int. J. Pharm. 2010, 397, 164–172. [Google Scholar] [CrossRef]
- Abdelbary, G.A.; Aburahma, M.H. Oro-dental mucoadhesive proniosomal gel formulation loaded with lornoxicam for management of dental pain. J. Liposome Res. 2015, 25, 107–121. [Google Scholar] [CrossRef]
- Aziz, D.E.; Abdelbary, A.A.; Elassasy, A.I. Fabrication of novel elastosomes for boosting the transdermal delivery of diacerein: Statistical optimization, ex-vivo permeation, in-vivo skin deposition and pharmacokinetic assessment compared to oral formulation. Drug Deliv. 2018, 25, 815–826. [Google Scholar] [CrossRef] [PubMed] [Green Version]
- Aburahma, M.H. Bile salts-containing vesicles: Promising pharmaceutical carriers for oral delivery of poorly water-soluble drugs and peptide/protein-based therapeutics or vaccines. Drug Deliv. 2016, 23, 1847–1867. [Google Scholar] [CrossRef] [PubMed]
- Niu, M.; Tan, Y.; Guan, P.; Hovgaard, L.; Lu, Y.; Qi, J.; Lian, R.; Li, X.; Wu, W. Enhanced oral absorption of insulin-loaded liposomes containing bile salts: A mechanistic study. Int. J. Pharm. 2014, 460, 119–130. [Google Scholar] [CrossRef] [PubMed]
- Qi, J.; Dai, Y.; Zhou, R.; Lu, Y.; Wu, W.; Liu, L. Liposomes containing bile salts as novel ocular delivery systems for tacrolimus (FK506): In vitro characterization and improved corneal permeation. Int. J. Nanomed. 2013, 8, 1921–1933. [Google Scholar] [CrossRef] [Green Version]
- Coviello, T.; Matricardi, P.; Marianecci, C.; Alhaique, F. Polysaccharide hydrogels for modified release formulations. J. Control. Release 2007, 119, 5–24. [Google Scholar] [CrossRef]
- Shukr, M.H.; Ismail, S.; El-Hossary, G.G.; El-Shazly, A.H. Design and evaluation of mucoadhesive in situ liposomal gel for sustained ocular delivery of travoprost using two steps factorial design. J. Drug Deliv. Sci. Technol. 2021, 61, 102333. [Google Scholar] [CrossRef]
- Morsi, N.; Ibrahim, M.; Refai, H.; El Sorogy, H. Nanoemulsion-based electrolyte triggered in situ gel for ocular delivery of acetazolamide. Eur. J. Pharm. Sci. 2017, 104, 302–314. [Google Scholar] [CrossRef]
- Gupta, P.; Yadav, K.S. Formulation and evaluation of brinzolamide encapsulated niosomal in-situ gel for sustained reduction of IOP in rabbits. J. Drug Deliv. Sci. Technol. 2022, 67, 103004. [Google Scholar] [CrossRef]
- Yu, S.; Li, Q.; Li, Y.; Wang, H.; Liu, D.; Yang, X.; Pan, W. A novel hydrogel with dual temperature and pH responsiveness based on a nanostructured lipid carrier as an ophthalmic delivery system: Enhanced trans-corneal permeability and bioavailability of nepafenac. New J. Chem. 2017, 41, 3920–3929. [Google Scholar] [CrossRef]
- Youssef, A.; Dudhipala, N.; Majumdar, S. Ciprofloxacin Loaded Nanostructured Lipid Carriers Incorporated into In-Situ Gels to Improve Management of Bacterial Endophthalmitis. Pharmaceutics 2020, 12, 572. [Google Scholar] [CrossRef]
- Agnihotri, S.M.; Vavia, P.R. Diclofenac-loaded biopolymeric nanosuspensions for ophthalmic application. Nanomed. Nanotechnol. Biol. Med. 2009, 5, 90–95. [Google Scholar] [CrossRef] [PubMed]
- Han, S.; Shen, J.-Q.; Gan, Y.; Geng, H.-M.; Zhang, X.-X.; Zhu, C.-L.; Gan, L. Novel vehicle based on cubosomes for ophthalmic delivery of flurbiprofen with low irritancy and high bioavailability. Acta Pharmacol. Sin. 2010, 31, 990–998. [Google Scholar] [CrossRef] [PubMed]
- Saettone, M.F.; Chetoni, P.; Cerbai, R.; Mazzanti, G.; Braghiroli, L. Evaluation of ocular permeation enhancers: In vitro effects on corneal transport of four [beta]-blockers and in vitro/in vivo toxic activity. Int. J. Pharm. 1996, 142, 103–113. [Google Scholar] [CrossRef]
- Mohammadi, M.; Elahimehr, Z.; Mahboobian, M.M. Acyclovir-Loaded Nanoemulsions: Preparation, Characterization and Irri-tancy Studies for Ophthalmic Delivery. Curr Eye Res. 2021, 46, 1646–1652. [Google Scholar] [CrossRef] [PubMed]
- Abdelbary, A.; Salem, H.F.; Khallaf, R.A.; Ali, A.M.A. Mucoadhesive niosomal in situ gel for ocular tissue targeting: In vitro and in vivo evaluation of lomefloxacin hydrochloride. Pharm. Dev. Technol. 2017, 22, 409–417. [Google Scholar] [CrossRef]
- Ignatova, M.; Manolova, N.; Rashkov, I. Electrospun Antibacterial Chitosan-Based Fibers. Macromol. Biosci. 2013, 13, 860–872. [Google Scholar] [CrossRef]
- Sannasiddappa, T.H.; Lund, P.A.; Clarke, S.R. In Vitro Antibacterial Activity of Unconjugated and Conjugated Bile Salts on Staphylococcus aureus. Front. Microbiol. 2017, 8, 1581. [Google Scholar] [CrossRef] [Green Version]
- Yilmaz Atay, H. Antibacterial Activity of Chitosan-Based Systems. In Functional Chitosan; Springer: Singapore, 2020; pp. 457–489. [Google Scholar]
- Nagy, A.; Harrison, A.; Sabbani, S.; Munson, R.S., Jr.; Dutta, P.K.; Waldman, W.J. Silver nanoparticles embedded in zeolite membranes: Release of silver ions and mechanism of antibacterial action. Int. J. Nanomed. 2011, 6, 1833–1852. [Google Scholar] [CrossRef] [Green Version]
- Ahmed, S.; Kassem, M.A.; Sayed, S. Bilosomes as Promising Nanovesicular Carriers for Improved Transdermal Delivery: Con-struction, in vitro Optimization, ex vivo Permeation and in vivo Evaluation. Int. J. Nanomed. 2020, 15, 9783–9798. [Google Scholar] [CrossRef]
- Lorenzo, F.; Navaratnam, S.; Edge, R.; Allen, N.S. Primary Photophysical Properties of Moxifloxacin- A Fluoroquinolone Antibiotic. Photochem. Photobiol. 2008, 84, 1118–1125. [Google Scholar] [CrossRef]
- Ammar, H.O.; Mohamed, M.I.; Tadros, M.I.; Fouly, A.A. Transdermal Delivery of Ondansetron Hydrochloride via Bilosomal Systems: In Vitro, Ex Vivo, and In Vivo Characterization Studies. AAPS PharmSciTech 2018, 19, 2276–2287. [Google Scholar] [CrossRef] [PubMed]
- Shahab, M.S.; Rizwanullah, M.; Alshehri, S.; Imam, S.S. Optimization to development of chitosan decorated polycaprolactone na-noparticles for improved ocular delivery of dorzolamide: In vitro, ex vivo and toxicity assessments. Int. J. Biol. Macromol. 2020, 163, 2392–2404. [Google Scholar] [CrossRef]
- Wichitnithad, W.; Kiatkumjorn, T.; Jithavech, P.; Thanawattanawanich, P.; Na Bhuket, P.R.; Rojsitthisak, P. A simple and sensitive HPLC-fluorescence method for the determination of moxifloxacin in human plasma and its application in a pharmacokinetic study. Pharmazie 2018, 73, 625–629. [Google Scholar] [PubMed]
- Kalweit, S.; Besoke, R.; Gerner, I.; Spielmann, H. A national validation project of alternative methods to the Draize rabbit eye test. Toxicol. Vitr. 1990, 4, 702–706. [Google Scholar] [CrossRef]

| Formulation Code | Bile Salt (mg) | Edge Activator (mg) | Surfactant (mg) | Hydrodynamic Diameter (nm) | Entrapment Efficiency (%) | Polydispersity Index |
|---|---|---|---|---|---|---|
| A | B | C | Y1 | Y2 | Y3 | |
| MX-BS1 | 15 | 7 | 45 | 166 | 78 | 0.22 |
| MX-BS2 | 30 | 7 | 45 | 191 | 73 | 0.38 |
| MX-BS3 | 15 | 15 | 45 | 183 | 84 | 0.24 |
| MX-BS4 | 30 | 15 | 45 | 245 | 63 | 0.37 |
| MX-BS5 | 15 | 11 | 30 | 196 | 67 | 0.24 |
| MX-BS6 | 30 | 11 | 30 | 318 | 45 | 0.47 |
| MX-BS7 | 15 | 11 | 60 | 218 | 91 | 0.15 |
| MX-BS8 | 30 | 11 | 60 | 187 | 88 | 0.21 |
| MX-BS9 | 22.5 | 7 | 30 | 251 | 53 | 0.39 |
| MX-BS10 | 22.5 | 15 | 30 | 245 | 58 | 0.41 |
| MX-BS11 | 22.5 | 7 | 60 | 158 | 95 | 0.21 |
| MX-BS12 | 22.5 | 15 | 60 | 233 | 86 | 0.21 |
| MX-BS13 * | 22.5 | 11 | 45 | 195 | 78 | 0.28 |
| MX-BS14 * | 22.5 | 11 | 45 | 195 | 77 | 0.29 |
| MX-BS15 * | 22.5 | 11 | 45 | 193 | 76 | 0.28 |
| MX-BS16 * | 22.5 | 11 | 45 | 199 | 78 | 0.28 |
| MX-BS17 * | 22.5 | 11 | 45 | 192 | 76 | 0.28 |
| Formulation | CH (%) | SA (%) | Clarity | Optical Transmittance (%) | Gelling Strength | Viscosity | Drug Content (%) | ||
|---|---|---|---|---|---|---|---|---|---|
| Sol | Gel | Solution | Gel | ||||||
| MX-BSop-Ig1 | 0.35 | 0.1 | Clear | 96.7 ± 1.5 | − | − | 8.4 ± 1.6 | 28.4 ± 3.8 | 97.5 ± 2.7 |
| MX-BSop-Ig2 | 0.35 | 0.2 | Clear | 97.3 ± 2.4 | − | + | 32.5 ± 3.7 | 133.6 ± 3.1 | 97.9 ± 2.7 |
| MX-BSop-Ig3 | 0.35 | 0.3 | Clear | 96.3 ± 2.5 | − | ++ | 50.4 ± 1.7 | 166.3 ± 3.1 | 98.8 ± 1.4 |
| MX-BSop-Ig4 | 0.35 | 0.4 | Clear | 97.0 ± 1.4 | − | +++ | 73.4 ± 5.3 | 287.5±10.5 | 99.1 ± 1.2 |
| MX-BSop-Ig5 | 0.35 | 0.5 | Turbid | 80.2 ± 2.3 | + | ++++ | 98.5 ± 2.1 | 314.7 ± 1.3 | 99.2 ± 2.0 |
| Independent Variables | Units | Level | ||
|---|---|---|---|---|
| Low (−) | Medium (0) | High (+) | ||
| Bile salt (SDC as A) | (mg) | 15 | 22.5 | 30 |
| Edge activator (Cremophor EL as B) | (mg) | 7 | 11 | 15 |
| Surfactant (Span 60 as C) | (mg) | 30 | 45 | 60 |
| Dependent variables | ||||
| Hydrodynamic diameter (Y1) | nm | |||
| Encapsulation efficiency (Y2) | % | |||
| Polydispersity index (PDI) (Y3) | ||||
Publisher’s Note: MDPI stays neutral with regard to jurisdictional claims in published maps and institutional affiliations. |
© 2022 by the authors. Licensee MDPI, Basel, Switzerland. This article is an open access article distributed under the terms and conditions of the Creative Commons Attribution (CC BY) license (https://creativecommons.org/licenses/by/4.0/).
Share and Cite
Zafar, A.; Alsaidan, O.A.; Imam, S.S.; Yasir, M.; Alharbi, K.S.; Khalid, M. Formulation and Evaluation of Moxifloxacin Loaded Bilosomes In-Situ Gel: Optimization to Antibacterial Evaluation. Gels 2022, 8, 418. https://doi.org/10.3390/gels8070418
Zafar A, Alsaidan OA, Imam SS, Yasir M, Alharbi KS, Khalid M. Formulation and Evaluation of Moxifloxacin Loaded Bilosomes In-Situ Gel: Optimization to Antibacterial Evaluation. Gels. 2022; 8(7):418. https://doi.org/10.3390/gels8070418
Chicago/Turabian StyleZafar, Ameeduzzafar, Omar Awad Alsaidan, Syed Sarim Imam, Mohd Yasir, Khalid Saad Alharbi, and Mohammad Khalid. 2022. "Formulation and Evaluation of Moxifloxacin Loaded Bilosomes In-Situ Gel: Optimization to Antibacterial Evaluation" Gels 8, no. 7: 418. https://doi.org/10.3390/gels8070418
APA StyleZafar, A., Alsaidan, O. A., Imam, S. S., Yasir, M., Alharbi, K. S., & Khalid, M. (2022). Formulation and Evaluation of Moxifloxacin Loaded Bilosomes In-Situ Gel: Optimization to Antibacterial Evaluation. Gels, 8(7), 418. https://doi.org/10.3390/gels8070418

